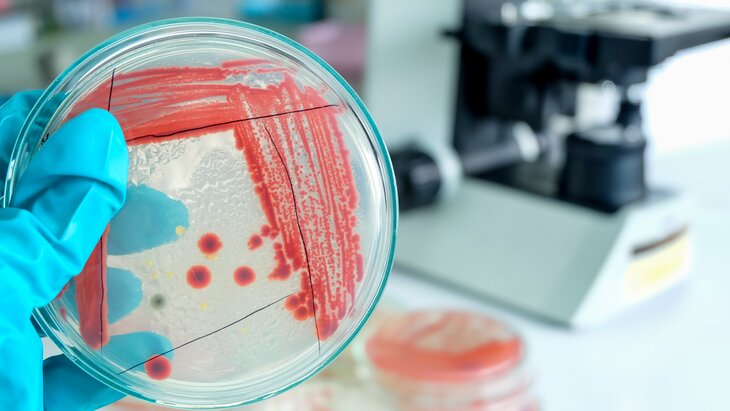

Новосибирские медики столкнулись с супербактериями
Фото: 123RF/tinydevil
Врачи Новосибирска все чаще сталкиваются с пациентами, для которых обычные антибиотики неэффективны. Супербактерии, обладающие устойчивостью к распространенным препаратам, смогли мутировать и выработать защиту. Об этом изданию НГС.ру рассказал фармаколог, заведующий кафедрой фармакологии, клинической фармакологии и доказательной медицины НГМУ Павел Мадонов.
Способы регуляции устойчивости бактерий
С момента разработки антибиотиков бактерии начали адаптироваться к выживанию. Этот процесс естественен, и его нельзя остановить. Поэтому для контроля ситуации препараты разделили на три группы: доступа (Access), наблюдения (Watch) и резерва (Reserve). Эта классификация, известная как AWaRe, была принята на встрече министров здравоохранения стран G20 в 2018 году.
Фармаколог добавил: новый целевой показатель для стран требует, чтобы не менее 60% антибиотиков принадлежали к группе доступа. Это должно хотя бы немного замедлить выработку устойчивости опасных бактерий.

Фото: 123RF/theshots
Почему важно завершать курс терапии
Фармаколог Павел Мадонов отметил, что в экономически развитых странах с большим количеством антибактериальных препаратов риск устойчивости выше. Он объяснил, что если антибиотик не уничтожает все бактерии, то оставшаяся клетка может передать свою защиту потомству, что приводит к мутации. Поэтому важно завершать курс терапии, чтобы избежать развития устойчивых штаммов.
Распространение супербактерий
Эксперт отметил: врачи уже сталкиваются с супербактериями, которые выработали устойчивость к группе доступа и еще целому ряду антибиотиков.
Также у бактерий есть природные враги – бактериофаги, но их применение ограничено из-за сложности дозировки, особенно у пациентов с заболеваниями почек.
Разработка новых антибиотиков
Павел Мадонов считает, что вероятность появления супербактерий, устойчивых ко всем антибиотикам, вряд ли реальна. Новые препараты разрабатываются, хотя и стоят дорого. В случае успешного создания резервного средства компании могут установить высокую цену, но после истечения патента появляются более доступные дженерики (препараты, которые в основе имеют то же количество и качество активного вещества, что и в оригинальном средстве, – "Доктор 24").
Ранее немецкие ученые заявили, что к 2050 году от инфекций могут умереть 39 миллионов человек во всем мире.
Старкина Маргарита



















